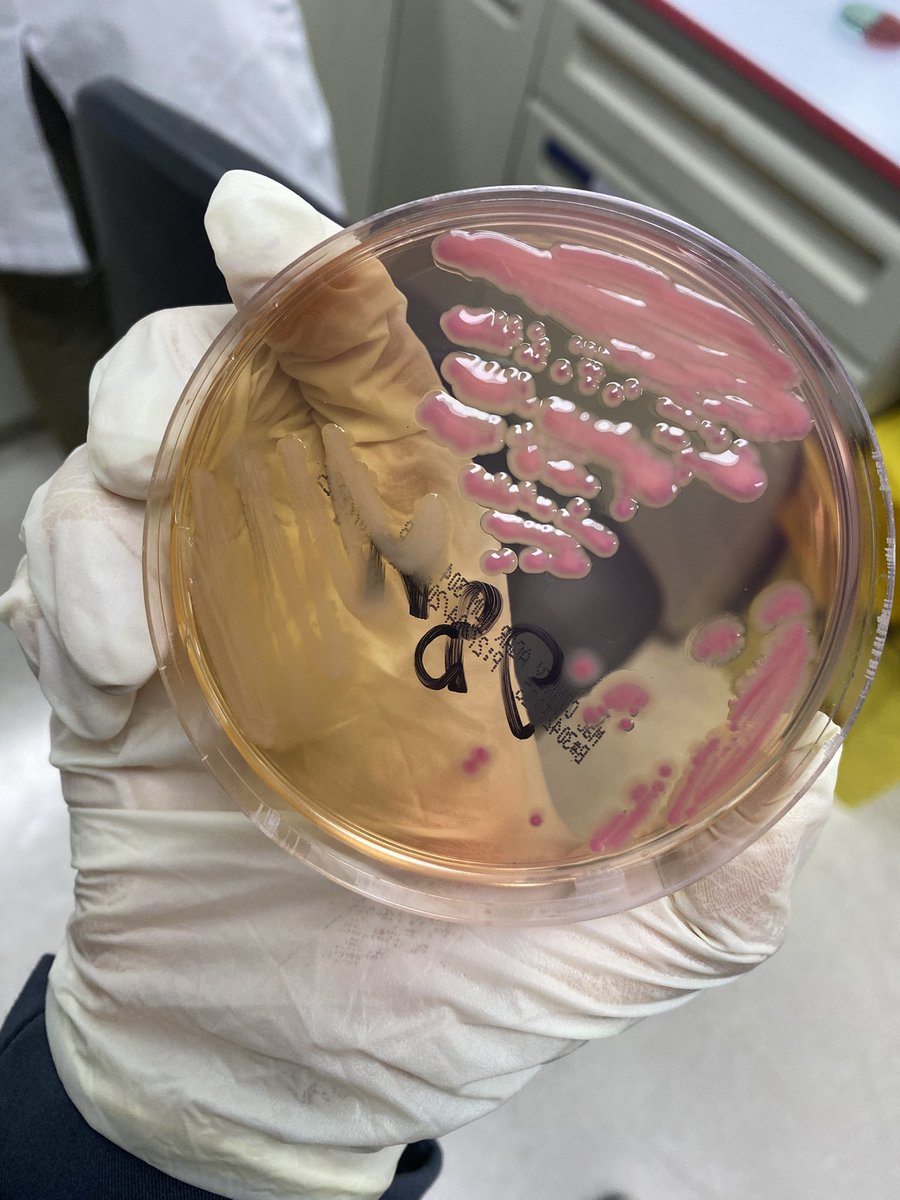
Bashayr tweet media

Bashayr
17 posts

Bashayr
@b1cls
CLS intern at @kfmc_taif
Kingdom of Saudi Arabia Katılım Şubat 2025
61 Takip Edilen65 Takipçiler

مشاركتي في اليوم العالمي للمختبرات بجامعة الطائف كانت في مختبر الهيماتولوجي
تجربه ممتعة ومميزه❤️
#اليوم_العالمي_للمختبرات_الطبية
#hematology




العربية